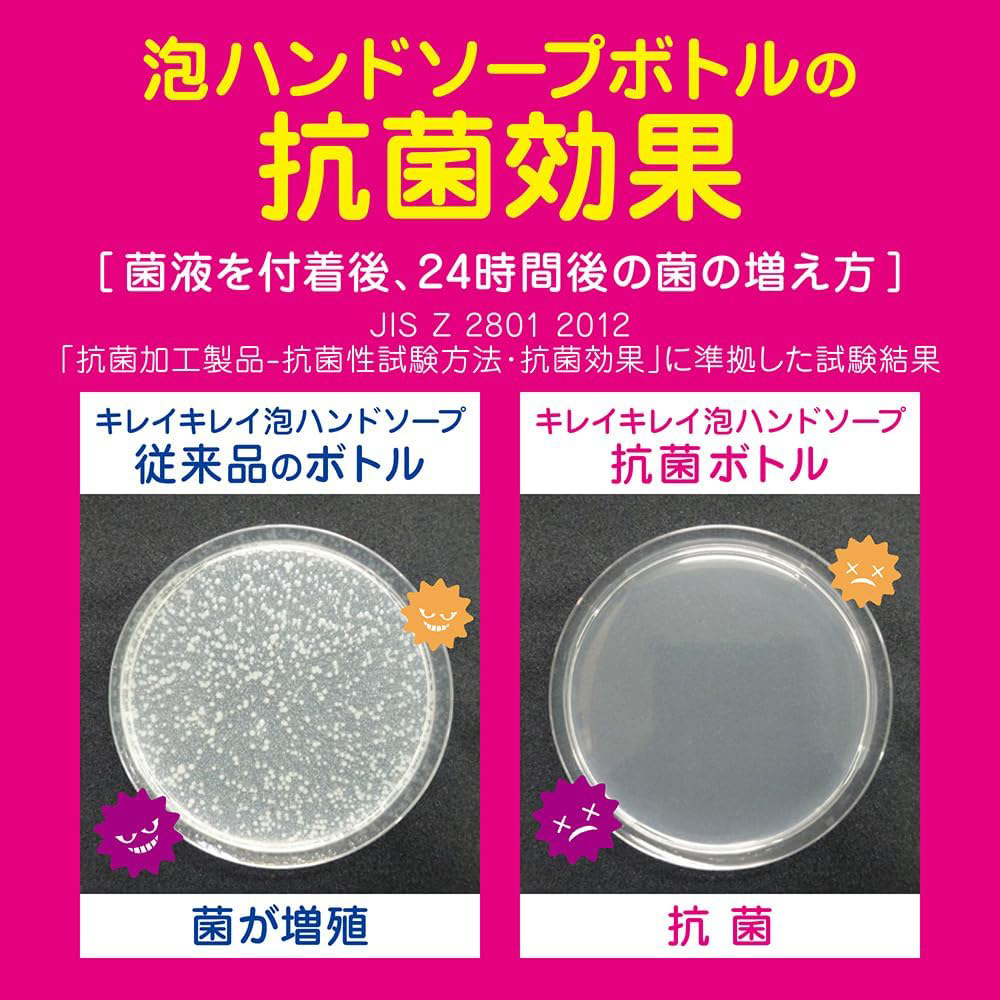
...

キレイキレイ 薬用泡ハンドソープ(シトラスフルーティの香り)/550mL(ライオンハイジーン) 收藏
一口价: 573 (合 27.62 人民币)
拍卖号:e1156426426
开始时间:11/26/2025 14:07:02
个 数:1
结束时间:12/03/2025 13:07:02
商品成色:新品
可否退货:不可
提前结束:不可
日本邮费:买家承担
自动延长:不可
最高出价:
出价次数:0

| 出价者 | 信用 | 价格 | 时间 |
|---|
推荐